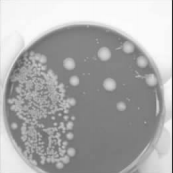

以糖类为原料,利用一种经遗传工程改造的微生物生产聚合物的方法,科学家发现了这一有望取代基于化石燃料的加工过程——
有益菌:经遗传工程改造的大肠杆菌(E.coli)可以产生塑料,有望取代基于化石燃料生产塑料的工艺
大肠杆菌(E.coli)能给你带来严重的食物中毒,但是用一些基因工程的技术对其进行改造后,它也能产生一种有用的塑料。最近,总部设在圣地亚哥的基诺麦迪卡公司(Genomatica Inc.)的科学家宣布,他们成功地利用细菌直接生产出了1,4-丁二醇(BDO)。这种化合物可用来制造很多用品,如氨纶、汽车保险杠等。因此,这就提供了一种不用石油或天然气就能生产出BDO的、更节能的方法。
基诺麦迪卡公司创始人之一、生物工程师兼总裁的克里斯托夫·希林(Christophe Schilling)说:“我们对这些有机体进行了遗传工程操作,这样它们会分泌出我们想要的产物来促进其生长。”基诺麦迪卡公司在2000年就开始培育这种化学物质(BDO)的细菌。“让我们感兴趣的地方在于:大肠杆菌分泌的产物越多,生长得就越快。”
这种大肠杆菌能够在大型发酵罐中大量生长(就像那些可从玉米中酿造酒精的大肠杆菌一样),并且通过遗传操作,它们能够耐受高浓度BDO的环境。希林说:“最初,很低浓度的BDO对大肠杆菌而言也是有毒的。但是现在,我们使它发生了演变,它能够生长在我们所需要的浓度环境里。我们让细菌在糖水中生长,以便制造我们想要的产物,然后从糖水中将产物分离、纯化出来。”
目前生产BDO的方法需要消耗大量的能源,希林及其同事开始尝试新的方法。全球最大的BDO生产商之一、德国化学巨头巴斯夫公司(BASF)在美国负责生产BDO的执行主管赫伯特·埃克斯纳(Herbert Exner)说:“生产这些化学品需要数量可观的能源。”
该公司进行了估算,他们的生产方式所需能源(包括了收集和运输:从食糖到纤维素等所有未加工的原料所需的全部能源)32000 British thermal units,简写为Btus(英国热量单位,1Btus=1055.06焦耳——译者注),比传统方式至少节省30%的能源。基诺麦迪卡公司的CEO克里斯托夫·甘恩(Christopher Gann)说,公司计划使用“便宜的、易得到的、非食物的和可再生的原料。”因为大肠杆菌可以在常压和40℃下,将这些“无用”的糖类转化成BDO;而传统的以石油为原料的BDO生产方式若是常温,就不能采用常压,反之亦然。
迄今为止,研究人员只生产了不到2磅的BDO。他们期待一个用于生产BDO的中试工厂能够在明年建成并投入使用。
巴斯夫公司的埃克斯纳说:“石油和天然气总有一天会消耗殆尽。但是主要的工业——例如汽车制造业——并不会只是因为你的产品贴上了生物标签,而甘愿掏更多的钱。”
现阶段要达到年产30亿磅相对便宜的BDO,基诺麦迪卡公司仍然有很长一段路要走。但是该公司指出,这种经遗传工程改造的大肠杆菌可以为将来制造必需的塑料复合物提供一种可持续的方式。
甘恩说:“我们选择从制造BDO开始,是因为这种化合物从石油和天然气到成品所需的步骤相对成熟;而我们以土地、水和阳光开始来制造BDO。这是我们最大的竞争优势——一种低能耗的、相当环保的制造方式。”